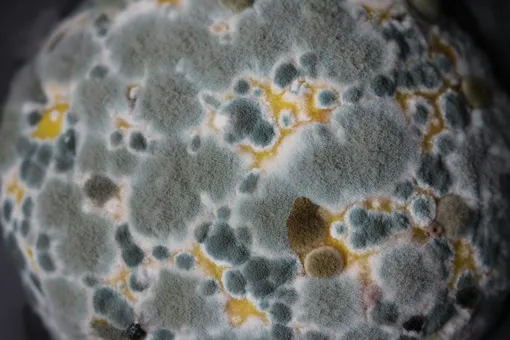

Зомбируют и вызывают радиацию: 8 фактов о грибах, которые вызывают шок
Обильные осадки и прохлада создали условия для активного роста грибов во многих регионах России. Биолог Мария Комбарова рассказала, как воздействует на грибы радиация и ультрафиолет, какие виды умеют охотиться и рыбачить, могут ли они превратить живых существ в зомби, действительно ли некоторые их представители умеют «ходить» и какие грибы особенно богаты витаминами и минералами.

Мария Комбарова
ведущий инженер, профессиональный биолог кафедры охраны окружающей среды ПНИПУ
Некоторые виды способны переносить огромные дозы радиации. Например, споры плесневых грибов пенициллы и аспергиллы расплодились на Международной космической станции (МКС) и выживают в условиях открытого космоса. Они постоянно подвергаются воздействию тяжелых ионов и рентгеновских лучей, уровень которых в десятки раз превышает смертельную дозу для человека.

Вблизи Чернобыльской АЭС ученые обнаружили грибы, которые научились питаться радиацией. Эти микроскопические виды проникли в почву вокруг станции и даже внутрь саркофага, накрывающего разрушенный реактор №4. Особенно их привлекает цезий-137 — изотоп, появившийся в результате взрыва энергоблока. Грибы используют его, чтобы быстрее развиваться и наращивать большую массу.
«В зоне Чернобыльской атомной станции часто можно встретить грибы неестественного вида. Слишком большой размер, например, указывает на мутацию, изменение генетической информации. Местные грибники рассказывают, что иногда вырастают грибы без шляпки или ножки — для таких особей размножение становится невозможным. Если им все же удалось рассеять споры, они будут поврежденными и погибнут», — рассказывает биолог Мария Комбарова.

Кстати, как и люди, грибы под влиянием ультрафиолета вырабатывают витамин D.

«От грибницы он пускает много маленьких «удочек» с петлей на конце. Петля схлопывается, когда попадается жертва, и гриб буквально высасывает все питательные вещества из добычи», — объясняет эксперт Пермского Политеха.
На суше живут подобные охотники и распускают свои сети в почве. Такие грибы, как навозники и вешенки, покрывают свою грибницу липким веществом. Когда черви-нематоды застревают в ловушке, гриб прорастает сквозь них. Некоторые виды вместо «клея» используют нечто вроде маленькой булавы: добыча напарывается на острые шипы, парализуется, и гриб постепенно впитывает ее в себя.

Грибы рода Cordyceps растут по всему миру в лесах тропиков, субтропиков и умеренного пояса. Попадая в организм насекомого (кузнечика, мухи, паука или муравья), гриб-паразит разрушает его мышечную и нервную системы и как бы управляет его поведением. Из-за этого носитель начинает вести себя неестественно: уходит подальше от муравейника и забирается на возвышенности, к примеру, на кончик травинки.
К этому моменту Cordyceps уже пророс сквозь весь организм муравья и выставил шляпку, несущую споры, наружу. Ветер подхватит рассеянные споры и разнесет по округе — так гриб поразит новую жертву.

«В качестве профилактики стоит чаще убираться в помещении и проветривать его. Нужно своевременно проводить ревизию продуктов в холодильнике, чтобы избежать появления белой пушистой плесени — ее споры особенно опасны. Несмотря на то, что грибковые заболевания легких — не слишком частое явление, избавиться от них очень сложно», — отмечает Мария Комбарова.

«Выглядят миксомицеты как комочки полупрозрачной слизи, порой у них можно различить даже ножку и шляпку, как у гриба. Если группа этих существ, называемая плазмодием, попадает в неблагоприятные условия или просто нуждается в смене места, она объединяется и начинает ползти», — добавляет биолог ПНИПУ.
Наши предки поджигали трутовики и в помещениях — дым от них хорошо отпугивает насекомых.Легко поджигаются именно мертвые, сухие грибы. Растущие содержат большое количество влаги, поэтому воспламенить свежесорванный трутовик не получится. Но есть и плюс: случайного пожара рядом с ними можно не бояться.
Важно помнить, что правила пожарной безопасности запрещают разводить костры в лесу.
Кстати, эти грибы считаются долгожителями и могут прожить до 80 лет. Их размер с годами увеличивается, масса самого большого известного трутовика — 500 кг. Столько весил двадцатилетний китайский трутовик длиной более 11 метров!

Растут эти грибы на многих деревьях: березе, осине, дубе, иве, клене, липе, хвойных деревьях. Лесники считают их санитарами леса, поскольку они разлагают умершие деревья и очищают лес от больных растений.
«Для здоровых особей трутовики представляют угрозу. Проникая спорами через повреждения коры, их грибница разрастается внутри дерева и питается веществами из него. Спустя некоторое время растение погибает, поскольку разрушается его структура. И использовать такую древесину в дальнейшем не получится», — отмечает Мария Комбарова.
Здоровью человека эти грибы могут как помочь, так и навредить. Среди съедобных трутовиков полезными свойствами выделяются:
березовый: бледно-коричневый гриб, в молодости напоминает мягкую булочку, в старости — копыто;
чешуйчатый: шляпка в виде большого веера, с крупными чешуйками;
серно-желтый: большие грибы оранжевого или желтоватого цвета.
Последний, кстати, по вкусу напоминает омлет и высоко ценится в Европе как деликатес. Из плодового тела грибов ученые выделили особый полисахарид, который при попадании в организм активизирует функции печени, заставляя ее более активно перерабатывать токсины и шлаки, расщеплять жиры.
Но аллергикам стоит быть осторожными во время прогулок по лесу — споры трутовиков могут вызывать реакцию.

Исследования показывают, что белые грибы являются лучшим стимулятором пищеварения, превосходя даже мясной бульон. Благодаря высокому содержанию полисахаридов и серы, белые грибы помогают в борьбе с онкологическими заболеваниями. Лецитин, содержащийся в них, препятствует отложению холестерина на стенках сосудов, а антиоксиданты помогают организму справляться с вирусами, грибками и бактериями.
Другие исследователи выделяют лисички, которые богаты витаминами B1, С, PP, микроэлементами и аминокислотами. Они также содержат бета-каротин, хром, цинк, кобальт и эргостерол — вещество, увеличивающее выработку витамина D. Удивительно, что содержание витамина А в этих грибах превышает его уровень в морковке. Они прекрасный источник витамина D2. Особенностью лисичек считается наличие хиноманнозы — активного вещества, способного бороться с паразитами и глистами.

Уникальное свойство лисичек заключается еще и в том, что они не накапливают радиоактивные вещества, а наоборот, способствуют выводу радионуклидов из организма. Поэтому эти грибы можно рассматривать как отличный продукт для профилактики рака и борьбы с воспалительными процессами.
«И еще один гриб, претендующий на звание короля грибов — опенок зимний, или фламулина. И действительно, гриб зимний: растет даже при минусовых температурах, так как имеет в своем составе масла, действующие как незамерзайка. Фламулина особо популярна в Японии и Китае, где ее искусственно выращивают и используют в народной медицине как противоопухолевое и противовоспалительное средство», — добавляет биолог Пермского Политеха.

Мария Комбарова
ведущий инженер, профессиональный биолог кафедры охраны окружающей среды ПНИПУ
Грибы могут выживать даже в экстремальных условиях
Их надземная часть, ножка и особенно шляпка, служат для созревания спор — репродуктивных структур. Они крайне устойчивы к неблагоприятным условиям, выживают в бескислородной среде, при засухе и замерзании.Некоторые виды способны переносить огромные дозы радиации. Например, споры плесневых грибов пенициллы и аспергиллы расплодились на Международной космической станции (МКС) и выживают в условиях открытого космоса. Они постоянно подвергаются воздействию тяжелых ионов и рентгеновских лучей, уровень которых в десятки раз превышает смертельную дозу для человека.
Вблизи Чернобыльской АЭС ученые обнаружили грибы, которые научились питаться радиацией. Эти микроскопические виды проникли в почву вокруг станции и даже внутрь саркофага, накрывающего разрушенный реактор №4. Особенно их привлекает цезий-137 — изотоп, появившийся в результате взрыва энергоблока. Грибы используют его, чтобы быстрее развиваться и наращивать большую массу.
«В зоне Чернобыльской атомной станции часто можно встретить грибы неестественного вида. Слишком большой размер, например, указывает на мутацию, изменение генетической информации. Местные грибники рассказывают, что иногда вырастают грибы без шляпки или ножки — для таких особей размножение становится невозможным. Если им все же удалось рассеять споры, они будут поврежденными и погибнут», — рассказывает биолог Мария Комбарова.

Грибы умеют загорать
Для развития грибам лучше подходят затемненные и влажные места. Хотя порой они растут на открытой местности, прямо под солнечными лучами. Споры грибов созревают именно в шляпке, а ультрафиолет и тепло могут ее иссушить. Чтобы этого не произошло, гриб реагирует на солнце так же, как кожа человека. Они активно вырабатывают меланин — пигмент коричневого цвета. Это помогает защититься от негативного воздействия лучей. Чем больше солнца, тем темнее шляпка.Кстати, как и люди, грибы под влиянием ультрафиолета вырабатывают витамин D.

Существуют грибы-хищники
Среди представителей грибного царства есть настоящие рыбаки. Например, обитающий в водоемах вид Zoophagus Tentaculum питается нематодами (микроскопическими червями) и может также поймать одноклеточный организм типа инфузории.«От грибницы он пускает много маленьких «удочек» с петлей на конце. Петля схлопывается, когда попадается жертва, и гриб буквально высасывает все питательные вещества из добычи», — объясняет эксперт Пермского Политеха.
На суше живут подобные охотники и распускают свои сети в почве. Такие грибы, как навозники и вешенки, покрывают свою грибницу липким веществом. Когда черви-нематоды застревают в ловушке, гриб прорастает сквозь них. Некоторые виды вместо «клея» используют нечто вроде маленькой булавы: добыча напарывается на острые шипы, парализуется, и гриб постепенно впитывает ее в себя.

Грибы рода Cordyceps превращают насекомых в зомби
Современная фантастика предложила множество версий зомби-апокалипсиса, в том числе — из-за заражения грибами. Доля правды в этой теории есть.Грибы рода Cordyceps растут по всему миру в лесах тропиков, субтропиков и умеренного пояса. Попадая в организм насекомого (кузнечика, мухи, паука или муравья), гриб-паразит разрушает его мышечную и нервную системы и как бы управляет его поведением. Из-за этого носитель начинает вести себя неестественно: уходит подальше от муравейника и забирается на возвышенности, к примеру, на кончик травинки.
К этому моменту Cordyceps уже пророс сквозь весь организм муравья и выставил шляпку, несущую споры, наружу. Ветер подхватит рассеянные споры и разнесет по округе — так гриб поразит новую жертву.

Грибы могут расти даже внутри легких человека
Микозам легких особенно подвержены люди со сниженной защитной реакцией организма: имеющие заболевания иммунной системы, онкологию, подвергшиеся воздействию антибиотиков широкого спектра и иммуносупрессоров. Возбудителями таких заболеваний являются микроскопические грибы и плесень, чьи споры попадают в дыхательные органы человека, прицепляются к их стенкам и размножаются, порой полностью забивая собой ткани легких.«В качестве профилактики стоит чаще убираться в помещении и проветривать его. Нужно своевременно проводить ревизию продуктов в холодильнике, чтобы избежать появления белой пушистой плесени — ее споры особенно опасны. Несмотря на то, что грибковые заболевания легких — не слишком частое явление, избавиться от них очень сложно», — отмечает Мария Комбарова.

Родственники грибов способны ходить
Миксомицеты, или слизевики — особый класс амебозоев (крупной группы простейших), который встречается как в северных широтах, так и в жарких регионах. К грибам их не относят, хотя они очень близки по многим признакам. Например, и те, и другие размножаются спорами, и изучают их те же ученые — микологи.«Выглядят миксомицеты как комочки полупрозрачной слизи, порой у них можно различить даже ножку и шляпку, как у гриба. Если группа этих существ, называемая плазмодием, попадает в неблагоприятные условия или просто нуждается в смене места, она объединяется и начинает ползти», — добавляет биолог ПНИПУ.
Грибы можно использовать для розжига костра
Еще наши предки использовали для розжига огня высохшие трутовики. Это условное название для группы грибов, которые растут преимущественно на древесине, стволах деревьев и даже опавших ветках. В них содержится большое количество целлюлозы, потому они легко воспламеняются. Кроме того, трутовики обладают хорошей способностью гореть долго и медленно.Наши предки поджигали трутовики и в помещениях — дым от них хорошо отпугивает насекомых.Легко поджигаются именно мертвые, сухие грибы. Растущие содержат большое количество влаги, поэтому воспламенить свежесорванный трутовик не получится. Но есть и плюс: случайного пожара рядом с ними можно не бояться.
Важно помнить, что правила пожарной безопасности запрещают разводить костры в лесу.
Кстати, эти грибы считаются долгожителями и могут прожить до 80 лет. Их размер с годами увеличивается, масса самого большого известного трутовика — 500 кг. Столько весил двадцатилетний китайский трутовик длиной более 11 метров!

Растут эти грибы на многих деревьях: березе, осине, дубе, иве, клене, липе, хвойных деревьях. Лесники считают их санитарами леса, поскольку они разлагают умершие деревья и очищают лес от больных растений.
«Для здоровых особей трутовики представляют угрозу. Проникая спорами через повреждения коры, их грибница разрастается внутри дерева и питается веществами из него. Спустя некоторое время растение погибает, поскольку разрушается его структура. И использовать такую древесину в дальнейшем не получится», — отмечает Мария Комбарова.
Здоровью человека эти грибы могут как помочь, так и навредить. Среди съедобных трутовиков полезными свойствами выделяются:
березовый: бледно-коричневый гриб, в молодости напоминает мягкую булочку, в старости — копыто;
чешуйчатый: шляпка в виде большого веера, с крупными чешуйками;
серно-желтый: большие грибы оранжевого или желтоватого цвета.
Последний, кстати, по вкусу напоминает омлет и высоко ценится в Европе как деликатес. Из плодового тела грибов ученые выделили особый полисахарид, который при попадании в организм активизирует функции печени, заставляя ее более активно перерабатывать токсины и шлаки, расщеплять жиры.
Но аллергикам стоит быть осторожными во время прогулок по лесу — споры трутовиков могут вызывать реакцию.
Грибы помогают защититься от простуды и даже рака
Насчет самого полезного гриба ученые спорят до сих пор. Кто-то выделяет белый гриб. Он назван так, потому что не темнеет даже после термической обработки. Этот вид не только низкокалорийный, но и легко усваивается — до 80% белка из сушеных белых грибов поглощается нашим организмом. По концентрации минералов он превосходит все другие.
Исследования показывают, что белые грибы являются лучшим стимулятором пищеварения, превосходя даже мясной бульон. Благодаря высокому содержанию полисахаридов и серы, белые грибы помогают в борьбе с онкологическими заболеваниями. Лецитин, содержащийся в них, препятствует отложению холестерина на стенках сосудов, а антиоксиданты помогают организму справляться с вирусами, грибками и бактериями.
Другие исследователи выделяют лисички, которые богаты витаминами B1, С, PP, микроэлементами и аминокислотами. Они также содержат бета-каротин, хром, цинк, кобальт и эргостерол — вещество, увеличивающее выработку витамина D. Удивительно, что содержание витамина А в этих грибах превышает его уровень в морковке. Они прекрасный источник витамина D2. Особенностью лисичек считается наличие хиноманнозы — активного вещества, способного бороться с паразитами и глистами.

Уникальное свойство лисичек заключается еще и в том, что они не накапливают радиоактивные вещества, а наоборот, способствуют выводу радионуклидов из организма. Поэтому эти грибы можно рассматривать как отличный продукт для профилактики рака и борьбы с воспалительными процессами.
«И еще один гриб, претендующий на звание короля грибов — опенок зимний, или фламулина. И действительно, гриб зимний: растет даже при минусовых температурах, так как имеет в своем составе масла, действующие как незамерзайка. Фламулина особо популярна в Японии и Китае, где ее искусственно выращивают и используют в народной медицине как противоопухолевое и противовоспалительное средство», — добавляет биолог Пермского Политеха.
Только зарегистрированные и авторизованные пользователи могут оставлять комментарии.
0
Всё это, конечно, интересно и познавательно (хотя и обсосано уже везде и всеми стопицот раз...). Но где же про грибы, которые вызывают шок??? Опять налюбили читателей?..
- ↓

